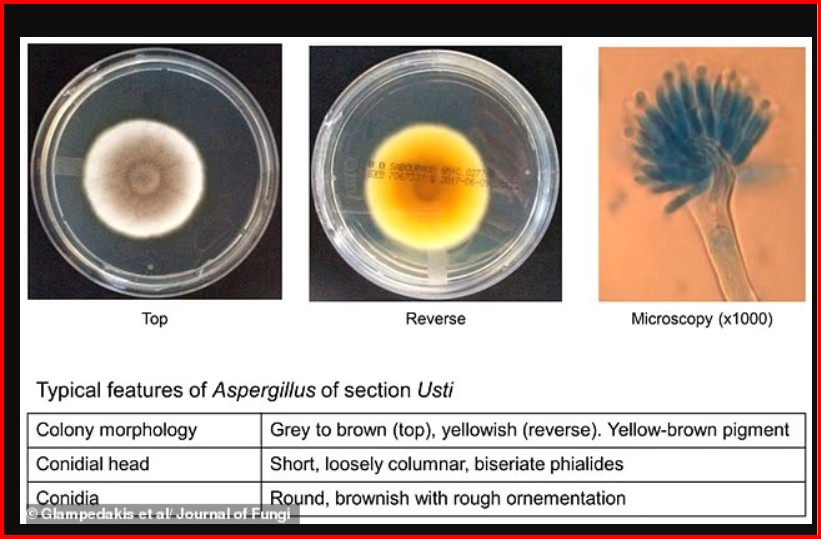

Shkencëtarët kanë zbuluar se disa forma të kërpudhave mikroskopike mund të mbijetojnë edhe në kushtet ekstreme të udhëtimit drejt Marsit, duke ngritur shqetësime të reja mbi rrezikun e kontaminimit të planetit të kuq.
Edhe pse kërpudhat njihen prej kohësh për rezistencën e tyre, një studim i ri sugjeron se disa prej tyre mund t’i mbijetojnë jo vetëm hapësirës, por edhe sipërfaqes së Marsit.
Studiuesit testuan mikroorganizma kërpudhorë në kushte që simulojnë rrezatimin ultravjollcë, temperaturat ekstreme të ftohta, presionin e ulët atmosferik dhe rrezatimin jonizues – faktorë që zakonisht shkatërrojnë shumicën e formave të jetës.
Një spore që i mbijetoi kushteve të Marsit
Rezultatet treguan se sporet e një kërpudhe të quajtur Aspergillus calidoustus arritën të mbijetonin.
Kjo kërpudhë është e njohur për rezistencën ndaj ilaçeve dhe mund të shkaktojë infeksione të rënda, veçanërisht tek personat me imunitet të dobësuar, si pacientët e transplantit.
Sipas studiuesve, kjo tregon se mikroorganizma të tillë mund të “udhëtojnë” drejt planetëve të tjerë dhe potencialisht të bëhen specie pushtuese.
Madje, ato arritën të mbijetojnë edhe në mjedise jashtëzakonisht sterile të NASA-s, të njohura si cleanrooms – hapësira të projektuara për të eliminuar çdo formë ndotjeje mikrobike.
Testime në kushte të hapësirës
Në studim, shkencëtarët analizuan mikroorganizma kërpudhorë të mbledhur nga këto ambiente sterile gjatë përgatitjes së misionit Mars 2020, që solli roverin Perseverance në Mars.
Ata krijuan spore riprodhuese nga 27 lloje kërpudhash dhe i ekspozuan ndaj kushteve të ngjashme me ato të hapësirës dhe sipërfaqes marsiane.

Sporet e A. calidoustus rezultuan ndër më rezistentet, duke i përballuar disa nga këto kushte ekstreme.
“Ky rezultat nuk do të thotë se kontaminimi i Marsit është i pashmangshëm, por na ndihmon të kuptojmë më mirë rreziqet e mbijetesës së mikroorganizmave,” tha drejtuesi i studimit Kasthuri Venkateswaran nga laboratorët e NASA-s.
Vetëm kombinimi i ekstremeve i shkatërron
Studiuesit zbuluan se vetëm kombinimi i temperaturave shumë të ulëta dhe rrezatimit të lartë ishte i mjaftueshëm për të shkatërruar kërpudhën.
Sipas tyre, mbijetesa e mikroorganizmave varet nga ndërveprimi i shumë faktorëve stresues dhe jo nga një element i vetëm.
Studimi, i publikuar në revistën Applied and Environmental Microbiology, forcon shqetësimet mbi nevojën për masa të rrepta të mbrojtjes planetare gjatë misioneve hapësinore.
Rreziku për kërkimin e jetës jashtëtokësore
Ekspertët paralajmërojnë se mikrobet tokësore mund të ngatërrohen me jetë jashtëtokësore, duke ndikuar në kërkime shkencore.
Gjithashtu ekziston rreziku që mikroorganizmat të kolonizojnë pajisjet mbështetëse të jetës për astronautët, duke krijuar probleme serioze në misione afatgjata.
Shkencëtari Christopher Mason ka theksuar më herët se transportimi i mikroorganizmave në planetë të tjerë mund të ketë pasoja të paparashikueshme për ekosistemet e reja.
Mikroorganizma të panjohura në Tokë
Në studime të tjera, janë zbuluar edhe 26 lloje bakteresh të panjohura më parë në ambientet sterile të Qendrës Hapësinore Kennedy në Florida.
Analizat treguan se këto mikroorganizma kanë aftësi të mbijetojnë në mjedise ekstreme, duke përfshirë mekanizma për rezistencë ndaj rrezatimit dhe riparim të ADN-së së tyre.
Zbulimet nënvizojnë nevojën për kontrolle edhe më të rrepta në misionet hapësinore, për të shmangur çdo rrezik të kontaminimit ndërplanetar. /GazetaExpress/